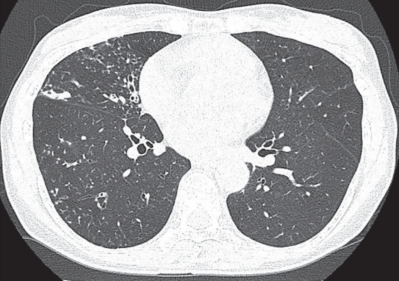
#

46 歳の女性。血痰を主訴に来院した。約 2 年前から咳嗽と喀痰を自覚していた。徐々に喀痰が増え、 2 日前から血痰が出現したため受診した。
身長 160 cm、体重 44 kg。体温 37.0 ℃。脈拍 80/分、整。血圧 124/72 mmHg。呼吸数 20/分。SpO₂ 98 %(room air)。右前胸部に rhonchi を聴取する。喀痰検査で Ziehl-Neelsen染色が陽性であったが、結核菌 PCR 検査は陰性であった。血液検査で抗 MAC〈Mycobacterium avium complex〉抗体が陽性であった。胸部単純 CTを別に示す。
この患者で正しいのはどれか。
a. 抗菌薬単剤治療を避ける。
b. 治療は 6 か月間が基本である。
c. ヒトへ感染させる可能性がある。
d. 菌が検出されたら直ちに治療を開始する。
e. 土壌や水系などの自然環境には存在しない菌による。